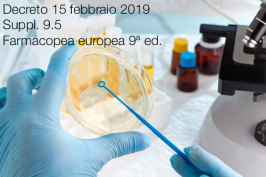
Decreto 15 febbraio 2019 | Suppl. 9.5 Farmacopea europea 9ª ed.

Decreto 15 febbraio 2019 | Suppl. 9.5 Farmacopea europea 9ª ed.
Decreto 15 febbraio 2019 | Suppl. 9.5 Farmacopea europea 9ª ed.
Decreto 15 Febbraio
Entrata in vigore dei testi, nelle lingue inglese e francese, pubblicati nel Supplemento 9.5 della…
Leggi tutto Decreto 15 febbraio 2019 | Suppl. 9.5 Farmacopea europea 9ª ed.Regolamento delegato (UE) 2019/330
Regolamento delegato (UE) 2019/330
Regolamento delegato (UE) 2019/330 della Commissione dell'11 dicembre 2018 che modifica gli allegati I e V del regolamento (UE) n. 649/2012del Parlamento europeo e del Consiglio sull'esportazione e importazione di…
Leggi tutto Regolamento delegato (UE) 2019/330Regolamento delegato (UE) 2019/157

Regolamento delegato (UE) 2019/157
Regolamento delegato (UE) 2019/157 della Commissione del 6 novembre 2018 che modifica l'allegato II del regolamento delegato (UE) n. 1062/2014relativo al programma di lavoro per l'esame sistematico di tutti i principi…
Leggi tutto Regolamento delegato (UE) 2019/157Regolamento (UE) 2019/37

Regolamento (UE) 2019/37
della Commissione del 10 gennaio 2019 che modifica e rettifica il regolamento (UE) n. 10/2011riguardante i materiali e gli oggetti di materia plastica destinati a venire a contatto con…
Leggi tutto Regolamento (UE) 2019/37Decisione di esecuzione (UE) 2018/2013

Decisione di esecuzione (UE) 2018/2013
della Commissione del 14 dicembre 2018 relativa all'identificazione dell'1,7,7-trimetil-3(fenilmetilene)biciclo[2.2.1]eptan-2-one (3-benzilidene canfora) come sostanza estremamente preoccupante a norma dell'articolo 57, lettera f), del regolamento (CE) n. 1907/2006del…
Leggi tutto Decisione di esecuzione (UE) 2018/2013Direttiva 82/501/CEE
Direttiva 82/501/CEE (Seveso I)
Direttiva 82/501/CEE del Consiglio, del 24 giugno 1982, sui rischi di incidenti rilevanti connessi con determinate attività industriali
GU L 230 del 5.8.1982
Attuata da: D.P.R. n. 175 del 17 maggio 1988
Abrogata da:
Direttiva 96/82/CE - Seveso II
Direttiva 2012/18/UE - Seveso III
Regolamento (UE) 2018/1847

Regolamento (UE) 2018/1847
della Commissione del 26 novembre 2018 che modifica l'allegato V del regolamento (CE) n. 1223/2009 del Parlamento europeo e del Consiglio sui prodotti cosmetici
GU L 300/1 del 27.11.2018…
Leggi tutto Regolamento (UE) 2018/1847Regolamento (UE) 2018/1513 | Modifica Allegato XVII REACH

Regolamento (UE) 2018/1513 | Modifica Allegato XVII REACH
Regolamento (UE) 2018/1513 della Commissione del 10 ottobre 2018 che modifica l'allegato XVII del regolamento (CE) n. 1907/2006del Parlamento europeo e del Consiglio concernente la registrazione,…
Leggi tutto Regolamento (UE) 2018/1513 | Modifica Allegato XVII REACHREACH Authorisation Decisions List: Last update 28.02.2019

REACH Authorisation Decisions List
REACH Authorisation Decisions List of authorisation decisions adopted on the basis of Article 64 of Regulation (EC) No 1907/2006 (REACH). The list also includes reference to related documentation…
Leggi tutto REACH Authorisation Decisions List: Last update 28.02.2019Decreto 21 dicembre 2018
Decreto 21 dicembre 2018
Aggiornamento dell'allegato 13 al decreto 29 aprile 2010, n. 75, recante: «Riordino e revisione della disciplina in materia di fertilizzanti, a norma dell'articolo 13 della legge 7…
Leggi tutto Decreto 21 dicembre 2018REACH Authorisation Decisions List: Last update 14.01.2019

REACH Authorisation Decisions List
REACH Authorisation Decisions List of authorisation decisions adopted on the basis of Article 64 of Regulation (EC) No 1907/2006 (REACH). The list also includes reference to related documentation…
Leggi tutto REACH Authorisation Decisions List: Last update 14.01.2019Comunicazione 2018/C 239/03
Comunicazione 2018/C 239/03
Comunicazione relativa alla classificazione di «pece, catrame di carbone, alta temperatura» tra le sostanze a tossicità acquatica acuta di categoria 1 e a tossicità acquatica cronica di categoria 1 in conformità del regolamento (CE) n. 1272/2008 del Parlamento europeo e del Consiglio (2018/C 239/03)
GU C 239/3 del 9.7.2018
Collegati
Regolamento (UE) 2018/2005 Modifica Allegato XVII REACH

Regolamento (UE) 2018/2005
della Commissione del 17 dicembre 2018 che modifica l'allegato XVII del regolamento (CE) n. 1907/2006 del Parlamento europeo e del Consiglio concernente la registrazione, la valutazione, l'autorizzazione e…
Leggi tutto Regolamento (UE) 2018/2005 Modifica Allegato XVII REACHRegolamento (UE) 2018/1881

Regolamento (UE) 2018/1881
della Commissione del 3 dicembre 2018 che modifica il regolamento (CE) n. 1907/2006del Parlamento europeo e del Consiglio concernente la registrazione, la valutazione, l'autorizzazione e la restrizione delle sostanze…
Leggi tutto Regolamento (UE) 2018/1881Decreto 27 settembre 2018

Decreto 27 settembre 2018 / Buone pratiche di fabbricazione cosmetici
Procedure di controllo del mercato interno dei prodotti cosmetici, ivi inclusi i controlli dei prodotti stessi, degli operatori di settore e…
Leggi tutto Decreto 27 settembre 2018Regolamento (UE) 2018/1480

CLP Allegato VI - XIII Adeguamento al progresso tecnico (ATP)
Regolamento (UE) 2018/1480
Regolamento (UE) 2018/1480 della Commissione del 4 ottobre 2018 recante modifica, ai fini dell'adeguamento al progresso tecnico e scientifico, del…
Leggi tutto Regolamento (UE) 2018/1480










































